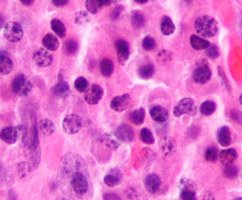

56ª ASH e as novidades da oncohematologia mundial
 Aconteceu no Moscone Center em São Francisco, Califórnia, a 56ª edição do encontro anual da ASH, a conferência da Sociedade Americana de Hematologia. Este ano, de 6 a 9 de dezembro a ASH apresentou mais de 3 mil abstracts, entre a exibição de pôsteres e apresentações orais , com as últimas novidades da oncohematologia mundial. Veja o que foi destaque na ASH 2014.
Aconteceu no Moscone Center em São Francisco, Califórnia, a 56ª edição do encontro anual da ASH, a conferência da Sociedade Americana de Hematologia. Este ano, de 6 a 9 de dezembro a ASH apresentou mais de 3 mil abstracts, entre a exibição de pôsteres e apresentações orais , com as últimas novidades da oncohematologia mundial. Veja o que foi destaque na ASH 2014.



 O estudo de fase III RESONATE e o ensaio de fase II RESONATE-17, desenhado para avaliar a eficácia e segurança do ibrutinibe no tratamento da Leucemia Linfocítica Crônica (LLC) recorrente ou refratária, apresentaram na 56ª ASH dados que mostram os benefícios desse agente terapêutico na população geral de pacientes e principalmente no subgrupo com deleção do cromossomo 17 (del 17p), variante agressiva da doença. O oncohematologista Marcelo Eduardo Zanella Capra comenta com exclusividade para o Onconews os resultados do RESONATE-17.
O estudo de fase III RESONATE e o ensaio de fase II RESONATE-17, desenhado para avaliar a eficácia e segurança do ibrutinibe no tratamento da Leucemia Linfocítica Crônica (LLC) recorrente ou refratária, apresentaram na 56ª ASH dados que mostram os benefícios desse agente terapêutico na população geral de pacientes e principalmente no subgrupo com deleção do cromossomo 17 (del 17p), variante agressiva da doença. O oncohematologista Marcelo Eduardo Zanella Capra comenta com exclusividade para o Onconews os resultados do RESONATE-17. O estudo randomizado DASISION confirmou nesta 56ª ASH a superioridade do dasatinibe em comparação com imatinibe em pacientes com Leucemia Mieloide Crônica em fase crônica (LMC-CP), sem tratamento prévio.
O estudo randomizado DASISION confirmou nesta 56ª ASH a superioridade do dasatinibe em comparação com imatinibe em pacientes com Leucemia Mieloide Crônica em fase crônica (LMC-CP), sem tratamento prévio. A 56ª ASH mostrou avanços para pacientes vulneráveis e com doença de difícil controle. É o caso de novas combinações de tratamentos e terapias direcionadas para linfoma e mieloma múltiplo, que estão entre os destaques desta edição anual. Apesar dos avanços nos tratamentos de linfoma, melhorar o prognóstico para pacientes com recidiva de doença e resistente ao tratamento ainda é um desafio.
A 56ª ASH mostrou avanços para pacientes vulneráveis e com doença de difícil controle. É o caso de novas combinações de tratamentos e terapias direcionadas para linfoma e mieloma múltiplo, que estão entre os destaques desta edição anual. Apesar dos avanços nos tratamentos de linfoma, melhorar o prognóstico para pacientes com recidiva de doença e resistente ao tratamento ainda é um desafio.  Os resultados da análise final do estudo CLL10 foram destaque na sessão plenária de sábado, na ASH 2014. O estudo foi liderado pelo grupo alemão (GCLLSG) e avaliou a quimioimunoterapia com fludarabina, ciclofosfamida e rituximabe versus bendamustina e rituximabe em pacientes com Leucemia Linfocítica Crônica (LLC), sem tratamento prévio. O oncohematologista Phillip Scheinberg comentou o estudo com exclusividade para o Onconews.
Os resultados da análise final do estudo CLL10 foram destaque na sessão plenária de sábado, na ASH 2014. O estudo foi liderado pelo grupo alemão (GCLLSG) e avaliou a quimioimunoterapia com fludarabina, ciclofosfamida e rituximabe versus bendamustina e rituximabe em pacientes com Leucemia Linfocítica Crônica (LLC), sem tratamento prévio. O oncohematologista Phillip Scheinberg comentou o estudo com exclusividade para o Onconews. O grupo de pesquisa alemão liderado por Christoph Röllig, de Dresden, apresentou na ASH 2014 os resultados do estudo SORAML, que mostra o papel de sorafenibe no tratamento de leucemia mieloide aguda (LMA).
O grupo de pesquisa alemão liderado por Christoph Röllig, de Dresden, apresentou na ASH 2014 os resultados do estudo SORAML, que mostra o papel de sorafenibe no tratamento de leucemia mieloide aguda (LMA). A 56ª ASH apresentou os resultados do estudo de fase III AETHERA, que investiga o uso do Brentuximabe Vedotin no tratamento de pacientes com Linfoma de Hodgkin com risco de progressão da doença, após o transplante autólogo.
A 56ª ASH apresentou os resultados do estudo de fase III AETHERA, que investiga o uso do Brentuximabe Vedotin no tratamento de pacientes com Linfoma de Hodgkin com risco de progressão da doença, após o transplante autólogo. Um estudo aberto, multicêntrico, de fase 1b, avaliou a combinação de daratumumab ao tratamento padrão no tratamento de mieloma múltiplo refratário ou resistente e concluiu que o agente melhora os resultados nesse subgrupo de pacientes.Os resultados positivos foram apresentados na 56ª ASH.
Um estudo aberto, multicêntrico, de fase 1b, avaliou a combinação de daratumumab ao tratamento padrão no tratamento de mieloma múltiplo refratário ou resistente e concluiu que o agente melhora os resultados nesse subgrupo de pacientes.Os resultados positivos foram apresentados na 56ª ASH.
